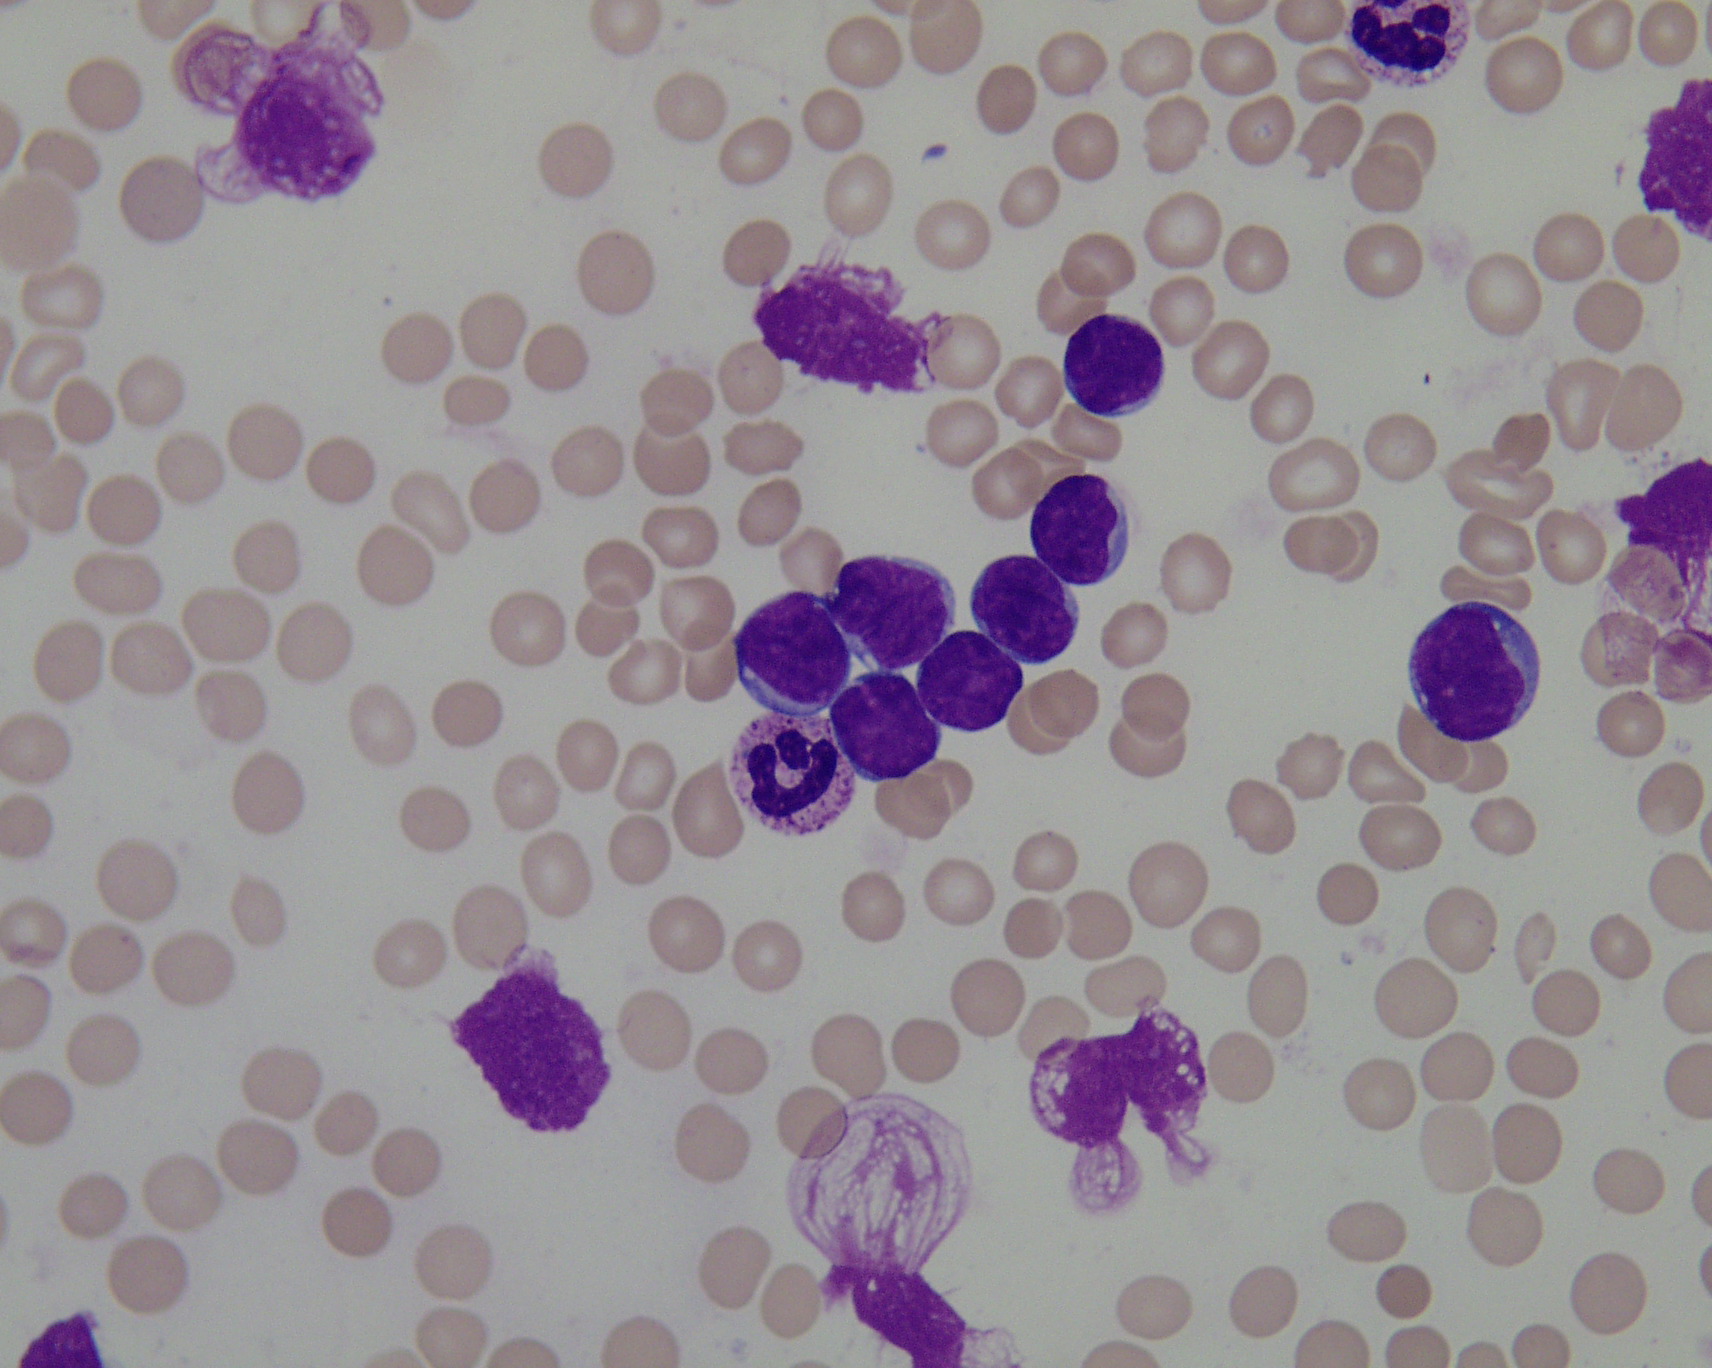

иты микроскопия это
Лейкоциты микроскопия это 102 фотографий
От чего пятки болят утром
Энгельс дергачи
Кауп 39
Материал сварочного костюма
Как мы расстались что это
Riko pacco 2 в 1
Hamster combat комбо 18 августа
Давление 130 80 форум
Пампушки дрожжевые в духовке
Такая модная мне так хорошо с тобой